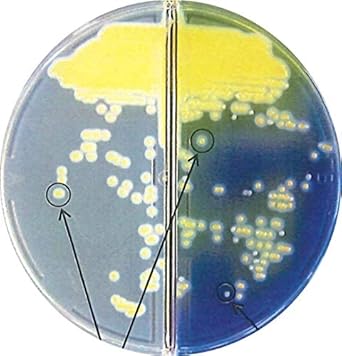
Amazon 日水製薬 生培地 ニッスイ分画 プレート p不含ms Cfx 変法卵黄加マンニット食塩ex寒天培地 100枚 寒天培地 産業 研究開発用品 通販
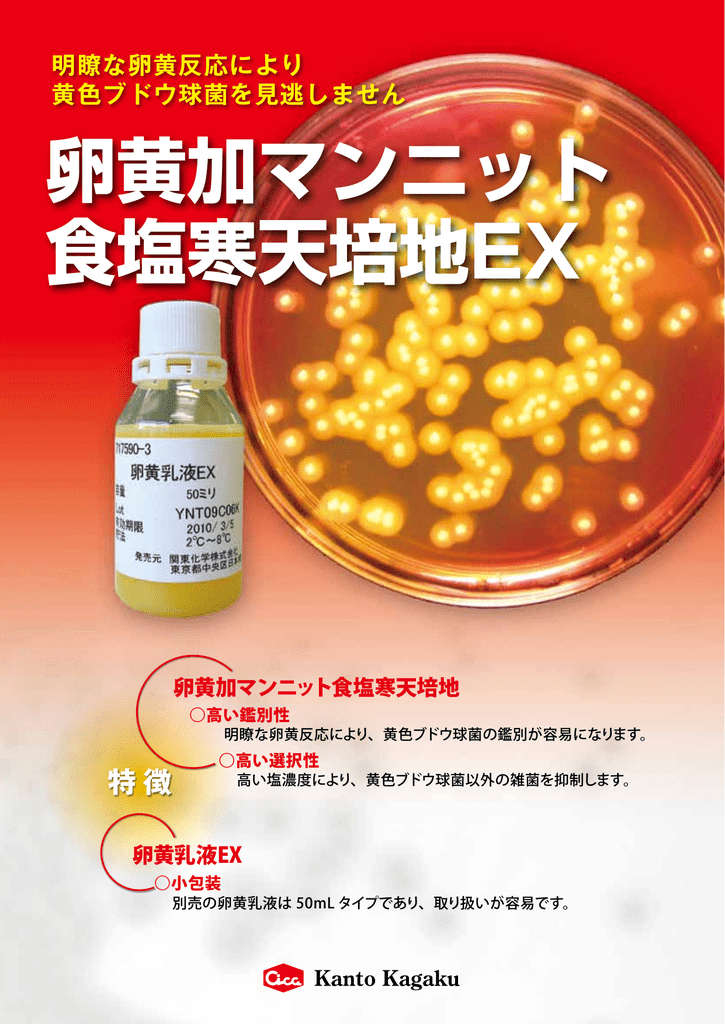
卵黄加マンニット 食塩寒天培地ex
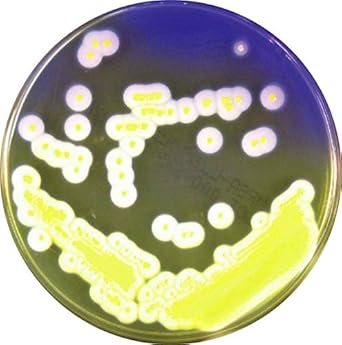
Amazon 日水製薬 生培地 ニッスイプレート 変法卵黄加マンニット食塩寒天培地ex 10枚 寒天培地 産業 研究開発用品 通販

√ダウンロード 卵黄 加 マン ニット 食塩 培地 702272
食塩卵寒天基礎培地 (ニッスイ) に卵黄液を加えた平板培地をお使いだと思いますが, 他社製品を含め, 同様の培地に共通した現象だと思います。これらの培地には高濃度に塩化ナトリウムが含まれており, 耐塩性菌を選択的に分離するよう工夫しており卵黄加マンニット食塩寒天培地Ⅱ_m110 スタンプスマン_m036 リパックシステム_m039 シカメディアシリーズ_m104 ダーラム管入調整済み液体培地_m109 シカメディアcp加ポテトブドウ糖寒天培地_m090(卵黄加マンニット食塩寒天培地) 一般生菌数(標準寒天培地) <衛生管理の指標> 一般生菌数 食品衛生法で定められた方法(標準寒天培地を用い、酸素の ある35℃の条件で48時間培養し、発育してくる菌を数える。) で検出される生きた菌の数。

栄養士科2年 食品衛生学実験 悠久山栄養調理専門学校 ブログ
卵黄 加 マン ニット 食塩 培地
卵黄 加 マン ニット 食塩 培地-マンニット食塩寒天培地にはマンニトールと指示薬としてのフェノールレッドが含まれる。 黄色ブドウ球菌 のような臨床的に重要な種のいくつかはマンニトール 発酵 を行い、酸を産生し、培地の色を赤色から黄色へと変化させる。栄研化学 ぺたんチェック(R)25 (卵黄加マンニット食塩寒天培地)/ wwwcasasruraleseltobarcom


Www Pref Niigata Lg Jp Uploaded Attachment Pdf
卵黄加マンニット食塩寒天培地 100枚 2~8℃ 卵黄加マンニット食塩寒天培地 枚 2~8℃ top 組成(精製水1リットルあたり) 肉エキス 10g カゼイン−スイ消化ペプトン栄研化学の生培地 ポアメディア 卵黄加マンニット食塩 8mr17の選定・通販ページ。ミスミ他、国内外3,324メーカー、2,070万点以上の商品を1個から送料無料で配送。豊富なcadデータ提供。栄研化学の生培地 ポアメディア 卵黄加マンニット食塩 8mr17を始め、fa・金型部品、工具・工場消耗品の通販直送品 アズワン 生培地卵黄加マンニット食塩寒天 《ライフサイエンス・分析》 一部の画像は代表画像です。商品内容をよくご確認の上ご用命くださいませ。 商品に関するご質問等は、お気軽にお問い合わせください。
マンニット食塩カンテン培地とセトリミドカンテン培地の培地性能試験について 受付 おり、現在微生物限度試験方法を日局15第1追補に変更するためのバリデーションを行っています。 質問はマンニット食塩カンテン培地とセトリミドカンテン培地の培地性能試験についてです。『卵黄加マンニット食塩培地』は、黄色ブドウ球菌の選択分離培地です。 各種検体材料から黄色ブドウ球菌の検出に使用します。 検体塗布後35℃培養で48時間培養します。 また、高濃度食塩含有によりブドウ球菌以外は発育がしません。 特長直送品 アズワン 生培地卵黄加マンニット食塩寒天 《ライフサイエンス・分析》 一部の画像は代表画像です。商品内容をよくご確認の上ご用命くださいませ。 商品に関するご質問等は、お気軽にお問い合わせください。
Nbrc 3060 nbrc 31 nbrc 3761 nbrc 3762 nbrc nbrc nbrc nbrc nbrc 138 nbrc nbrc nbrc(卵黄加)マンニット食塩寒天培地 対象 ・ Staphylococcus スタフィロコッカス spp 糖・pH指示薬 ・ マンニット ・ PR(フェノールレッド) 酸性条件で 黄色 ・中性条件で 橙色 ・アルカリ性条件で 赤色 を示します。 選択剤 ・ 75%塩化ナトリウム 備考ハンドぺたんチェックⅡ 卵黄加マンニット食塩培地 1枚×10袋 pt4040 pdf 黄色ブドウ球菌用 esコリブルー培地100ボトル 60本 ekw08 pdf 水質大腸菌検査用(100ml用) 厚生労働省令第101号、厚生労働省告示第261号 esコリブルー培地100チューブ


腸管系細菌 細菌の検査 各論 神奈川県衛生研究所



4 1127 03 サニスペック生培地 卵黄加マンニット食塩寒天 枚入 Axel アズワン
卵黄加マンニット食塩培地 sds 10枚 ¥1,700冷暗所(4~10℃) ・禁凍結 4ヶ月間 ニッスイプレート 卵黄加マンニット食塩培地 sds 100枚 受注生産 冷所(4~10℃) ・禁凍結 4ヶ月間 ニッスイプレート 変法卵黄加マンニット食塩寒天培地2通りの卵黄液について記載しましたが, 一般的に言われている卵黄加マンニット食塩培地は3%卵黄加マンニット食塩培地です。回答者の経験ですと, 2~5%の卵黄で十分に卵黄反応は確認できました。回答が長くなりましたが, 培地を溶かす水の量は, 添加する092sy ブドウ球菌の選択分離培地 ニッスイプレート卵黄加マンニット食塩培地 ニッスイプレート食塩卵寒天培地 黄色ブドウ球菌 黄色の集落を形成し、周辺の培地は卵黄反応によって、白濁と


Www Pref Kagawa Lg Jp Documents 25 8 Pdf


表皮ブドウ球菌 卵黄加マンニット食塩培地で 黄色ブドウ球菌が出た Yahoo 知恵袋
針では卵黄加マンニット食塩培地(msey)やベアー ド・パーカー培地(bp)を用いた検査法が記載されてい る.日本ではbpに比べてmseyを使用することが多 い웋웗.mseyは黄色ブドウ球菌の75%nacl存在下での 発育,マンニット分解性,卵黄反応陽性等の性状をアズワン サニスペック生培地 卵黄加マンニット食塩寒天 枚入 1箱(枚) (直送品) 販売単位: 1箱(枚) お申込番号: U卵黄加マンニット食塩培地 sds 10枚 ¥1,700冷暗所(4~10℃) ・禁凍結 4ヶ月間 ニッスイプレート 卵黄加マンニット食塩培地 sds 100枚 受注生産 冷所(4~10℃) ・禁凍結 4ヶ月間 ニッスイプレート 変法卵黄加マンニット食塩寒天培地


アテクトのeo液 Atect


食品衛生学実験 食品中の細菌測定法 神戸松蔭女子学院大学 食物栄養学科
対象培地 卵黄加マンニット食塩寒天培地 卵黄加ngkg寒天培地 マデック寒天培地(mlcb) tcbs寒天 入数 1枚/箱 材質 特殊プラスチック 送料 弊社負担 重量 250g 印刷して御使用下さい。(卵黄加)マンニット食塩寒天培地 対象 ・ Staphylococcus スタフィロコッカス spp 糖・pH指示薬 ・ マンニット ・ PR(フェノールレッド) 酸性条件で 黄色 ・中性条件で 橙色 ・アルカリ性条件で 赤色 を示します。 選択剤 ・ 75%塩化ナトリウム 備考卵黄加マンニット食塩寒天培地(MSEY寒天培地)集落の性状(37℃、二日培養後) 75%NaCl 耐性()。10~15 mmの不透明、中心がやや隆起した黄色集落 マンニット分解性():黄色集落 卵黄反応():集落周囲に混濁環ないし真珠様反応環を伴う。


Q Tbn And9gctp Lc2youcr2tqshy0u2euxlrku9uizms1v Kwzyntibfgaeks Usqp Cau



栄養士科2年 食品衛生学実験 悠久山栄養調理専門学校 ブログ
栄研化学の生培地 ポアメディア 卵黄加マンニット食塩 8mr17の選定・通販ページ。ミスミ他、国内外3,324メーカー、2,070万点以上の商品を1個から送料無料で配送。豊富なcadデータ提供。栄研化学の生培地 ポアメディア 卵黄加マンニット食塩 8mr17を始め、fa・金型部品、工具・工場消耗品の通販本培地は、食品・臨床材料等から Staphylococcus aureus を選択分離ならびに生菌数の測定に使用します。 Staphylococcus aureus はマンニットを分解し、集落周囲に卵黄反応が生じます。 Staphylococcus 属以外の細菌の発育は阻止します。 本培地は従来品に比べ、精製した卵黄液を使用する事により、卵黄反応・選択分離培地各2枚に希釈液01mLを塗抹する。(公定法) ベアードパーカー寒天培地 (卵黄加マンニット食塩寒天培地でも可) ・分離培養後に疑わしい集落をラテックスの凝集によって確認する。 迅速性・・・凝集反応を肉眼で迅速に判断(秒)



生培地 株式会社アテクト

Amazon 日水製薬 生培地 ニッスイ分画 プレート p不含ms Cfx 変法卵黄加マンニット食塩ex寒天培地 100枚 寒天培地 産業 研究開発用品 通販
培地性能試験を実施していますのでいつでも一定した高品質な培地を使用することができます。 細菌検査の初心者から熟練者の皆様まで幅広くお使い頂いています。 黄色ブドウ球菌用 卵黄加マンニット食塩寒天培地マンニット食塩寒天培地にはマンニトールと指示薬としてのフェノールレッドが含まれる。 黄色ブドウ球菌 のような臨床的に重要な種のいくつかはマンニトール 発酵 を行い、酸を産生し、培地の色を赤色から黄色へと変化させる。


栄研化学 ぺたんチェック R 25 卵黄加マンニット食塩寒天培地 6 9530 04 Supersport Tn



卵黄加マンニット食塩寒天培地 牛の獣医さん Commits 大動物臨床



Kn ぺたんチェック30枚入 セレウス菌用セレウス寒天培地 の販売価格と特徴 仕様 通販のテックジャム



食中毒検査 越谷市公式ホームページ



Kn ぺたんチェック40枚入 黄色ブドウ球菌用卵黄加マンニット食塩寒天培地 の販売価格と特徴 仕様 通販のテックジャム



Kn ぺたんチェック30枚入 黄色ブドウ球菌用卵黄加マンニット食塩寒天培地 の販売価格と特徴 仕様 通販のテックジャム


アズワン2 85 04サニスペック生培地 卵黄加マンニット食塩寒天 20枚入 箱 As1 2 85 04 Buyee Buyee 日本の通販商品 オークションの代理入札 代理購入



楽天市場 黄色ブドウ 寒天の通販



お問合せはこちらからお願い致します 株式会社セントラル科学貿易



食品工場で多数実績あり 卵黄加マンニット食塩寒天培地 コージンバイオ イプロス医薬食品技術



学籍番号 坂本明子 坂本陽子 佐藤寛美 副島ゆかり 立藤綾香 田中麻美 S B O 1 ブドウ球菌の細菌学的特徴 2 黄色ブドウ球菌の細菌学的特徴 3 黄色ブドウ球菌による病気を説明できる 4 感染の予防と診断と


Http Www Tokyo Eiken Go Jp Files Archive Issue Kenkyunenpo Nenpo58 01 04 Pdf


Q Tbn And9gcqgeb 6mhbt X7gzw4vsyn0hhaczog Vhkz0jnoix4sb3y Bivv Usqp Cau


食品ネット分析室 細菌一般



黄色ブドウ球菌用 卵黄加マンニット食塩寒天培地 株式会社アテクト

卵黄加マンニット 食塩寒天培地ex


Http 1 33 172 30 Products Technique Pamph 4061 Pdf



マンニット食塩寒天培地 Wikipedia



その他の食中毒菌検査 横浜市


Www Pref Niigata Lg Jp Uploaded Attachment Pdf


Products Kanto Co Jp Uploads Pj46 M Pdf 361 Pdf1 Pdf



Kn ぺたんチェック40枚入 黄色ブドウ球菌用卵黄加マンニット食塩寒天培地 の販売価格と特徴 仕様 通販のテックジャム


Www Eiken Co Jp Uploads Es10c Pdf



Amazon 日水製薬 環境微生物検査 クリーンスタンプ ニッスイ 卵黄加マンニット食塩培地 ブドウ球菌用 100枚 寒天培地 産業 研究開発用品 通販


黄色ブドウ球菌 検査結果の例 石川ラボシステムズ


Http Fasmac Co Jp Wp Wp Content Uploads 06 S Aureus Pdf



黄色ブドウ球菌検査用培地 食中毒起因菌用培地 食品 環境分野 微生物検査 関東化学株式会社


ぺたんチェック25 卵黄加マンニット食塩培地 Pt4025 カビ 細菌 環境測定項目 製品情報 株式会社アイデック



Amazon 日水製薬 環境微生物検査 クリーンスタンプ ニッスイ 卵黄加マンニット食塩培地 ブドウ球菌用 100枚 寒天培地 産業 研究開発用品 通販


Www Nite Go Jp Data Pdf


ポイント15倍 直送品 アズワン サニスペック生培地 卵黄加マンニット食塩寒天 枚入 4 1127 03 ライフサイエンス 分析 Azuw 4 1127 03 工具屋さんyahoo 店 通販 Yahoo ショッピング



l Tm 卵黄加マンニット食塩寒天培地 ベクトン ディッキンソン Axel アズワン


Products Kanto Co Jp Uploads Pj46 M Pdf 361 Pdf1 Pdf


Www Nissui Pharm Co Jp Pdf Products 510 P Pdf


卵黄加マンニット食塩寒天培地の細菌についてお聞きしたいです 先日 食品 Yahoo 知恵袋



l 卵黄加マンニット食塩寒天培地 日本bd



生培地 ポアメディア 卵黄加マンニット食塩 栄研化学 Misumi Vona ミスミ


Q Tbn And9gctfhlwzr7rrzi72hwwwbdwr4pfvz 0iijug9qsgyw3nldzlqzbt Usqp Cau



寒天培地の製造 販売 開発 日研生物 株式会社 日研生物医学研究所



卵黄加マンニット食塩寒天培地 黄色ブドウ球菌選択分離用 製品カタログ カタログ コージンバイオ Powered By イプロス



製品詳細 株式会社 日研生物 各種培地の製造 開発 販売 受託 培地メーカー


卵黄加マンニット食塩培地から白い変な菌



4 1127 03 サニスペック生培地 卵黄加マンニット食塩寒天 枚入 Axel アズワン



19年プライスリストvol 4 Pdf 無料ダウンロード



食中毒検査 越谷市公式ホームページ



フィルム培地 Medi Ca Sa ソリューション 製品 サービス Dnp 大日本印刷

Amazon 日水製薬 生培地 ニッスイプレート 変法卵黄加マンニット食塩寒天培地ex 10枚 寒天培地 産業 研究開発用品 通販



黄色ブドウ球菌と微生物検査の補足 食品の品質デザイナーをブランドに



Amazon 日水製薬 ニッスイプレート 卵黄加マンニット食塩培地 10枚 寒天培地 産業 研究開発用品 通販


Http Www Flippedbonkimura Com Wp Wp Content Uploads 03 0fa9a4c1d60b32d4738ae348d Pdf



卵黄加マンニット食塩培地 タニモト Powered By イプロス


Http Www Nikken Bio Co Jp Catalog Pdf 17rinsho Vol1 Pdf



生培地 株式会社アテクト


Http 1 33 172 30 Modern Media Backnumber Pdf Mm0804 05 Pdf


2


太洋株式会社 生培地 卵黄加マンニット食塩寒天枚入



日水製薬 コスモ会 クリーンスタンプ



食品検査用培地 黄色ブドウ球菌の分離用 卵黄加マンニット食塩 タニモト Powered By イプロス



Mrsa選択培地 日本bd



生培地 ポアメディア 卵黄加マンニット食塩 栄研化学 Misumi Vona ミスミ



毒素型食中毒菌検査 横浜市


17年7月発行 食品 添加物等の規格基準に定める黄色ブドウ球菌の試験法について



語呂合わせ まとめノートで国家試験対策するなら臨床検査技師への道



4 1127 03 サニスペック生培地 卵黄加マンニット食塩寒天 枚入 Axel アズワン



07 3000号 卵黄加培地 Astamuse


Www Atect Co Jp Cms Wp Content Uploads 18 10 Mannitol Pdf



製品詳細 株式会社 日研生物 各種培地の製造 開発 販売 受託 培地メーカー


腸管系細菌 細菌の検査 各論 神奈川県衛生研究所



Kbm 卵黄加マンニット食塩寒天培地 コージンバイオ株式会社



フィルム培地 Medi Ca Sa ソリューション 製品 サービス Dnp 大日本印刷



嬉しい相談 あくと らぼ



食中毒の原因となる微生物について 新潟市



Kbm 変法卵黄加マンニット寒天培地 コージンバイオ株式会社



Eo液 黄色ブドウ球菌用 株式会社アテクト


マンニット食塩寒天培地 日本bd



アスクル オリエンタル酵母工業 食品用寒天平板生培地 卵黄加マンニット 1箱 100枚 6 9729 13 直送品 通販 Askul 公式



卵黄加マンニット食塩寒天培地


Q Tbn And9gcrjwdb5n52dd7jz0frq2rg1pnfw0g7xfa 1bcc6qbtaibg3qynv Usqp Cau



4 1127 03 サニスペック生培地 卵黄加マンニット食塩寒天 枚入 Axel アズワン


Www Pref Kagawa Lg Jp Documents 25 8 Pdf


腸管系細菌 細菌の検査 各論 神奈川県衛生研究所


Cosmokai Com Youran Pdf


腸管系細菌 細菌の検査 各論 神奈川県衛生研究所



食中毒検査 越谷市公式ホームページ



学籍番号 坂本明子 坂本陽子 佐藤寛美 副島ゆかり 立藤綾香 田中麻美 S B O 1 ブドウ球菌の細菌学的特徴 2 黄色ブドウ球菌の細菌学的特徴 3 黄色ブドウ球菌による病気を説明できる 4 感染の予防と診断と



ぺたんチェック25 卵黄加マンニット食塩寒天培地 Pt4025 4枚 10袋



黄色ブドウ球菌と微生物検査の補足 食品の品質デザイナーをブランドに


黄色ブドウ球菌 検査結果の例 石川ラボシステムズ



お問合せはこちらからお願い致します 株式会社セントラル科学貿易



Tgk 東京硝子器械 Trywinz 卵黄加マンニット食塩培地 Pt4025 40入


腸管系細菌 細菌の検査 各論 神奈川県衛生研究所


食品ネット分析室 細菌の展覧会 11



取扱を終了した商品です サニスペックスタンプ培地 卵黄加マンニット寒天培地 2 3301 03 Axel アズワン



Amazon アズワン サニスペック生培地 卵黄加マンニット食塩寒天 100枚入 寒天培地 産業 研究開発用品 通販


コメント
コメントを投稿